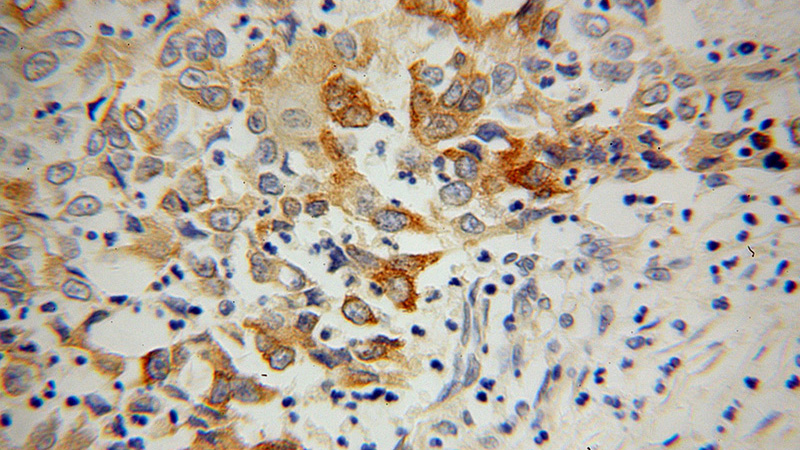
Immunohistochemical of paraffin-embedded human pancreas cancer using Catalog No:110310(EEF1A1 antibody) at dilution of 1:100 (under 40x lens)

-
Product Name
EEF1A1 antibody
- Documents
-
Description
EEF1A1 Rabbit Polyclonal antibody. Positive IF detected in Hela cells. Positive IHC detected in human pancreas cancer tissue. Positive WB detected in HepG2 cells, A431 cells, HEK-293 cells, HeLa cells, human brain tissue, Jurkat cells, MCF7 cells, mouse brain tissue, mouse heart tissue, mouse liver tissue, mouse ovary tissue, mouse pancreas tissue, mouse skeletal muscle tissue, multi-cells, rat brain tissue, SH-SY5Y cells. Observed molecular weight by Western-blot: 50 kDa
-
Tested applications
ELISA, WB, IHC, IF
-
Species reactivity
Human, Mouse, Rat; other species not tested.
-
Alternative names
CCS 3 antibody; CCS3 antibody; EEF 1 antibody; EEF1A antibody; eEF1A 1 antibody; EEF1A1 antibody; EF 1 alpha 1 antibody; EF Tu antibody; EF1A antibody; Elongation factor 1 alpha 1 antibody; Elongation factor Tu antibody; FLJ25721 antibody; GRAF 1EF antibody; HNGC:16303 antibody; LENG7 antibody; PTI1 antibody
-
Isotype
Rabbit IgG
-
Preparation
This antibody was obtained by immunization of EEF1A1 recombinant protein (Accession Number: NM_001402). Purification method: Antigen affinity purified.
-
Clonality
Polyclonal
-
Formulation
PBS with 0.1% sodium azide and 50% glycerol pH 7.3.
-
Storage instructions
Store at -20℃. DO NOT ALIQUOT
-
Applications
Recommended Dilution:
WB: 1:500-1:5000
IHC: 1:20-1:200
IF: 1:10-1:100
-
Validations

WB results of Catalog No:110310(anti-EEF1A1) in multiple cells.

HepG2 cells were subjected to SDS PAGE followed by western blot with Catalog No:110310(EEF1A1 antibody) at dilution of 1:1000

Immunohistochemical of paraffin-embedded human pancreas cancer using Catalog No:110310(EEF1A1 antibody) at dilution of 1:100 (under 10x lens)
Immunohistochemical of paraffin-embedded human pancreas cancer using Catalog No:110310(EEF1A1 antibody) at dilution of 1:100 (under 40x lens)

Immunofluorescent analysis of Hela cells, using EEF1A1 antibody Catalog No:110310 at 1:25 dilution and Rhodamine-labeled goat anti-rabbit IgG (red).
-
Background
EEF1A1, also named as EEF1A, EF1A and LENG7, belongs to the GTP-binding elongation factor family. This protein promotes the GTP-dependent binding of aminoacyl-tRNA to the A-site of ribosomes during protein biosynthesis. It is a typical housekeeping gene product required for the maintenance of cell growth and/or survival. In addition, EEF1A1 protects the aminoester bond against hydrolysis until a correct match between the codon on mRNA and the anti-codon on tRNA can be achieved. This antibody is a rabbit polyclonal antibody raised against residues near the C terminus of human EEF1A1.
-
References
- Mizuno K, Kojima Y, Kurokawa S. Identification of differentially expressed genes in human cryptorchid testes using suppression subtractive hybridization. The Journal of urology. 181(3):1330-7; discussion 1337. 2009.
- Bao H, Song P, Liu Q. Quantitative proteomic analysis of a paired human liver healthy versus carcinoma cell lines with the same genetic background to identify potential hepatocellular carcinoma markers. Proteomics. Clinical applications. 3(6):705-19. 2009.
Related Products / Services
Please note: All products are "FOR RESEARCH USE ONLY AND ARE NOT INTENDED FOR DIAGNOSTIC OR THERAPEUTIC USE"
